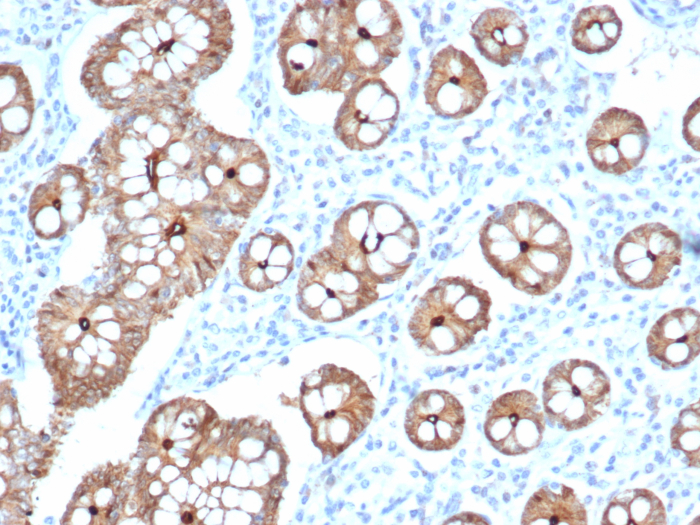
Villin 1 Antibody (VIL1/2310R) - Azide and BSA Free

Villin 1 Antibody (VIL1/2310R) - Azide and BSA Free
Novus Biologicals, part of Bio-Techne | Catalog # NBP3-08929
Recombinant Monoclonal Antibody

![Immunohistochemistry-Paraffin: Villin 1 Antibody (VIL1/2310R) - Azide and BSA Free [NBP3-08929] Immunohistochemistry-Paraffin: Villin 1 Antibody (VIL1/2310R) - Azide and BSA Free [NBP3-08929]](https://resources.bio-techne.com/images/products/Villin-1-Antibody-VIL1-2310R-Azide-and-BSA-Free-Immunohistochemistry-Paraffin-NBP3-08929-img0001.jpg)
Conjugate
Catalog #
Key Product Details
Species Reactivity
Human
Applications
Immunohistochemistry-Paraffin
Label
Unconjugated
Antibody Source
Recombinant Monoclonal Rabbit IgG Clone # VIL1/2310R
Format
Azide and BSA Free
Concentration
1 mg/ml
Product Specifications
Immunogen
A recombinant fragment (around aa179-311) of human Villin 1 protein (exact sequence is proprietary) (Uniprot: P09327)
Localization
Cytoplasmic & Cell Surface
Specificity
Recognizes a protein of 95kDa, which is identified as villin. It is a major constituent in the microvilli, which compose the brush border of epithelial cells forming absorptive surfaces of the intestinal and renal proximal tubular epithelia. Anti-Villin labels the brush border area in the gastrointestinal mucosal epithelium and urogenital tract. Among neoplasms, villin is predominantly expressed in tumors of colorectal origin. Antibody to villin is useful in identifying malignant cells from primary and metastatic colorectal carcinomas. This antibody also labels Merkel cells of the skin.
Marker
GI-Mucosal & Urogenital Brush Border Marker
Clonality
Monoclonal
Host
Rabbit
Isotype
IgG
Theoretical MW
93 kDa.
Disclaimer note: The observed molecular weight of the protein may vary from the listed predicted molecular weight due to post translational modifications, post translation cleavages, relative charges, and other experimental factors.
Disclaimer note: The observed molecular weight of the protein may vary from the listed predicted molecular weight due to post translational modifications, post translation cleavages, relative charges, and other experimental factors.
Description
1.0 mg/ml of antibody purified from Bioreactor Concentrate by Protein A/G. Prepared in 10mM PBS WITHOUT BSA & azide. Also available at 200 ug/ml WITH BSA & azide (NBP3-07184).
Antibody with azide - store at 2 to 8C. Antibody without azide - store at -20 to -80C.
Antibody with azide - store at 2 to 8C. Antibody without azide - store at -20 to -80C.
Scientific Data Images for Villin 1 Antibody (VIL1/2310R) - Azide and BSA Free
Immunohistochemistry-Paraffin: Villin 1 Antibody (VIL1/2310R) - Azide and BSA Free [NBP3-08929]
Immunohistochemistry-Paraffin: Villin 1 Antibody (VIL1/2310R) - Azide and BSA Free [NBP3-08929] - Formalin-fixed, paraffin-embedded human Small Intestine stained with Villin 1 Rabbit Recombinant Monoclonal Antibody (VIL1/2310R).Villin 1 Antibody (VIL1/2310R)
Western blot analysis of HepG2 cell lysate using Villin 1 antibody (VIL1/2310R).Villin 1 Antibody (VIL1/2310R)
Formalin-fixed, paraffin-embedded human colon stained with Villin 1 antibody (VIL1/2310R).Applications for Villin 1 Antibody (VIL1/2310R) - Azide and BSA Free
Application
Recommended Usage
Immunohistochemistry-Paraffin
1-2 ug/ml
Application Notes
Immunohistochemistry Formalin-fixed: 1-2ug/ml for 30 minutes at RT. Staining of formalin-fixed tissues requires heating tissue sections in 10mM Tris with 1mM EDTA, pH 9.0, for 45 min at 95C followed by cooling at RT for 20 minutes.
Formulation, Preparation, and Storage
Purification
Protein A or G purified
Formulation
10 mM PBS
Format
Azide and BSA Free
Preservative
No Preservative
Concentration
1 mg/ml
Shipping
The product is shipped with polar packs. Upon receipt, store it immediately at the temperature recommended below.
Stability & Storage
Store at -20 to -80C. Avoid freeze-thaw cycles.
Background: Villin 1
Alternate Names
D2S1471, VIL, villin 1, villin-1
Gene Symbol
VIL1
Additional Villin 1 Products
Product Documents for Villin 1 Antibody (VIL1/2310R) - Azide and BSA Free
Product Specific Notices for Villin 1 Antibody (VIL1/2310R) - Azide and BSA Free
This product is for research use only and is not approved for use in humans or in clinical diagnosis. Primary Antibodies are guaranteed for 1 year from date of receipt.
Loading...
Loading...
Loading...
Loading...